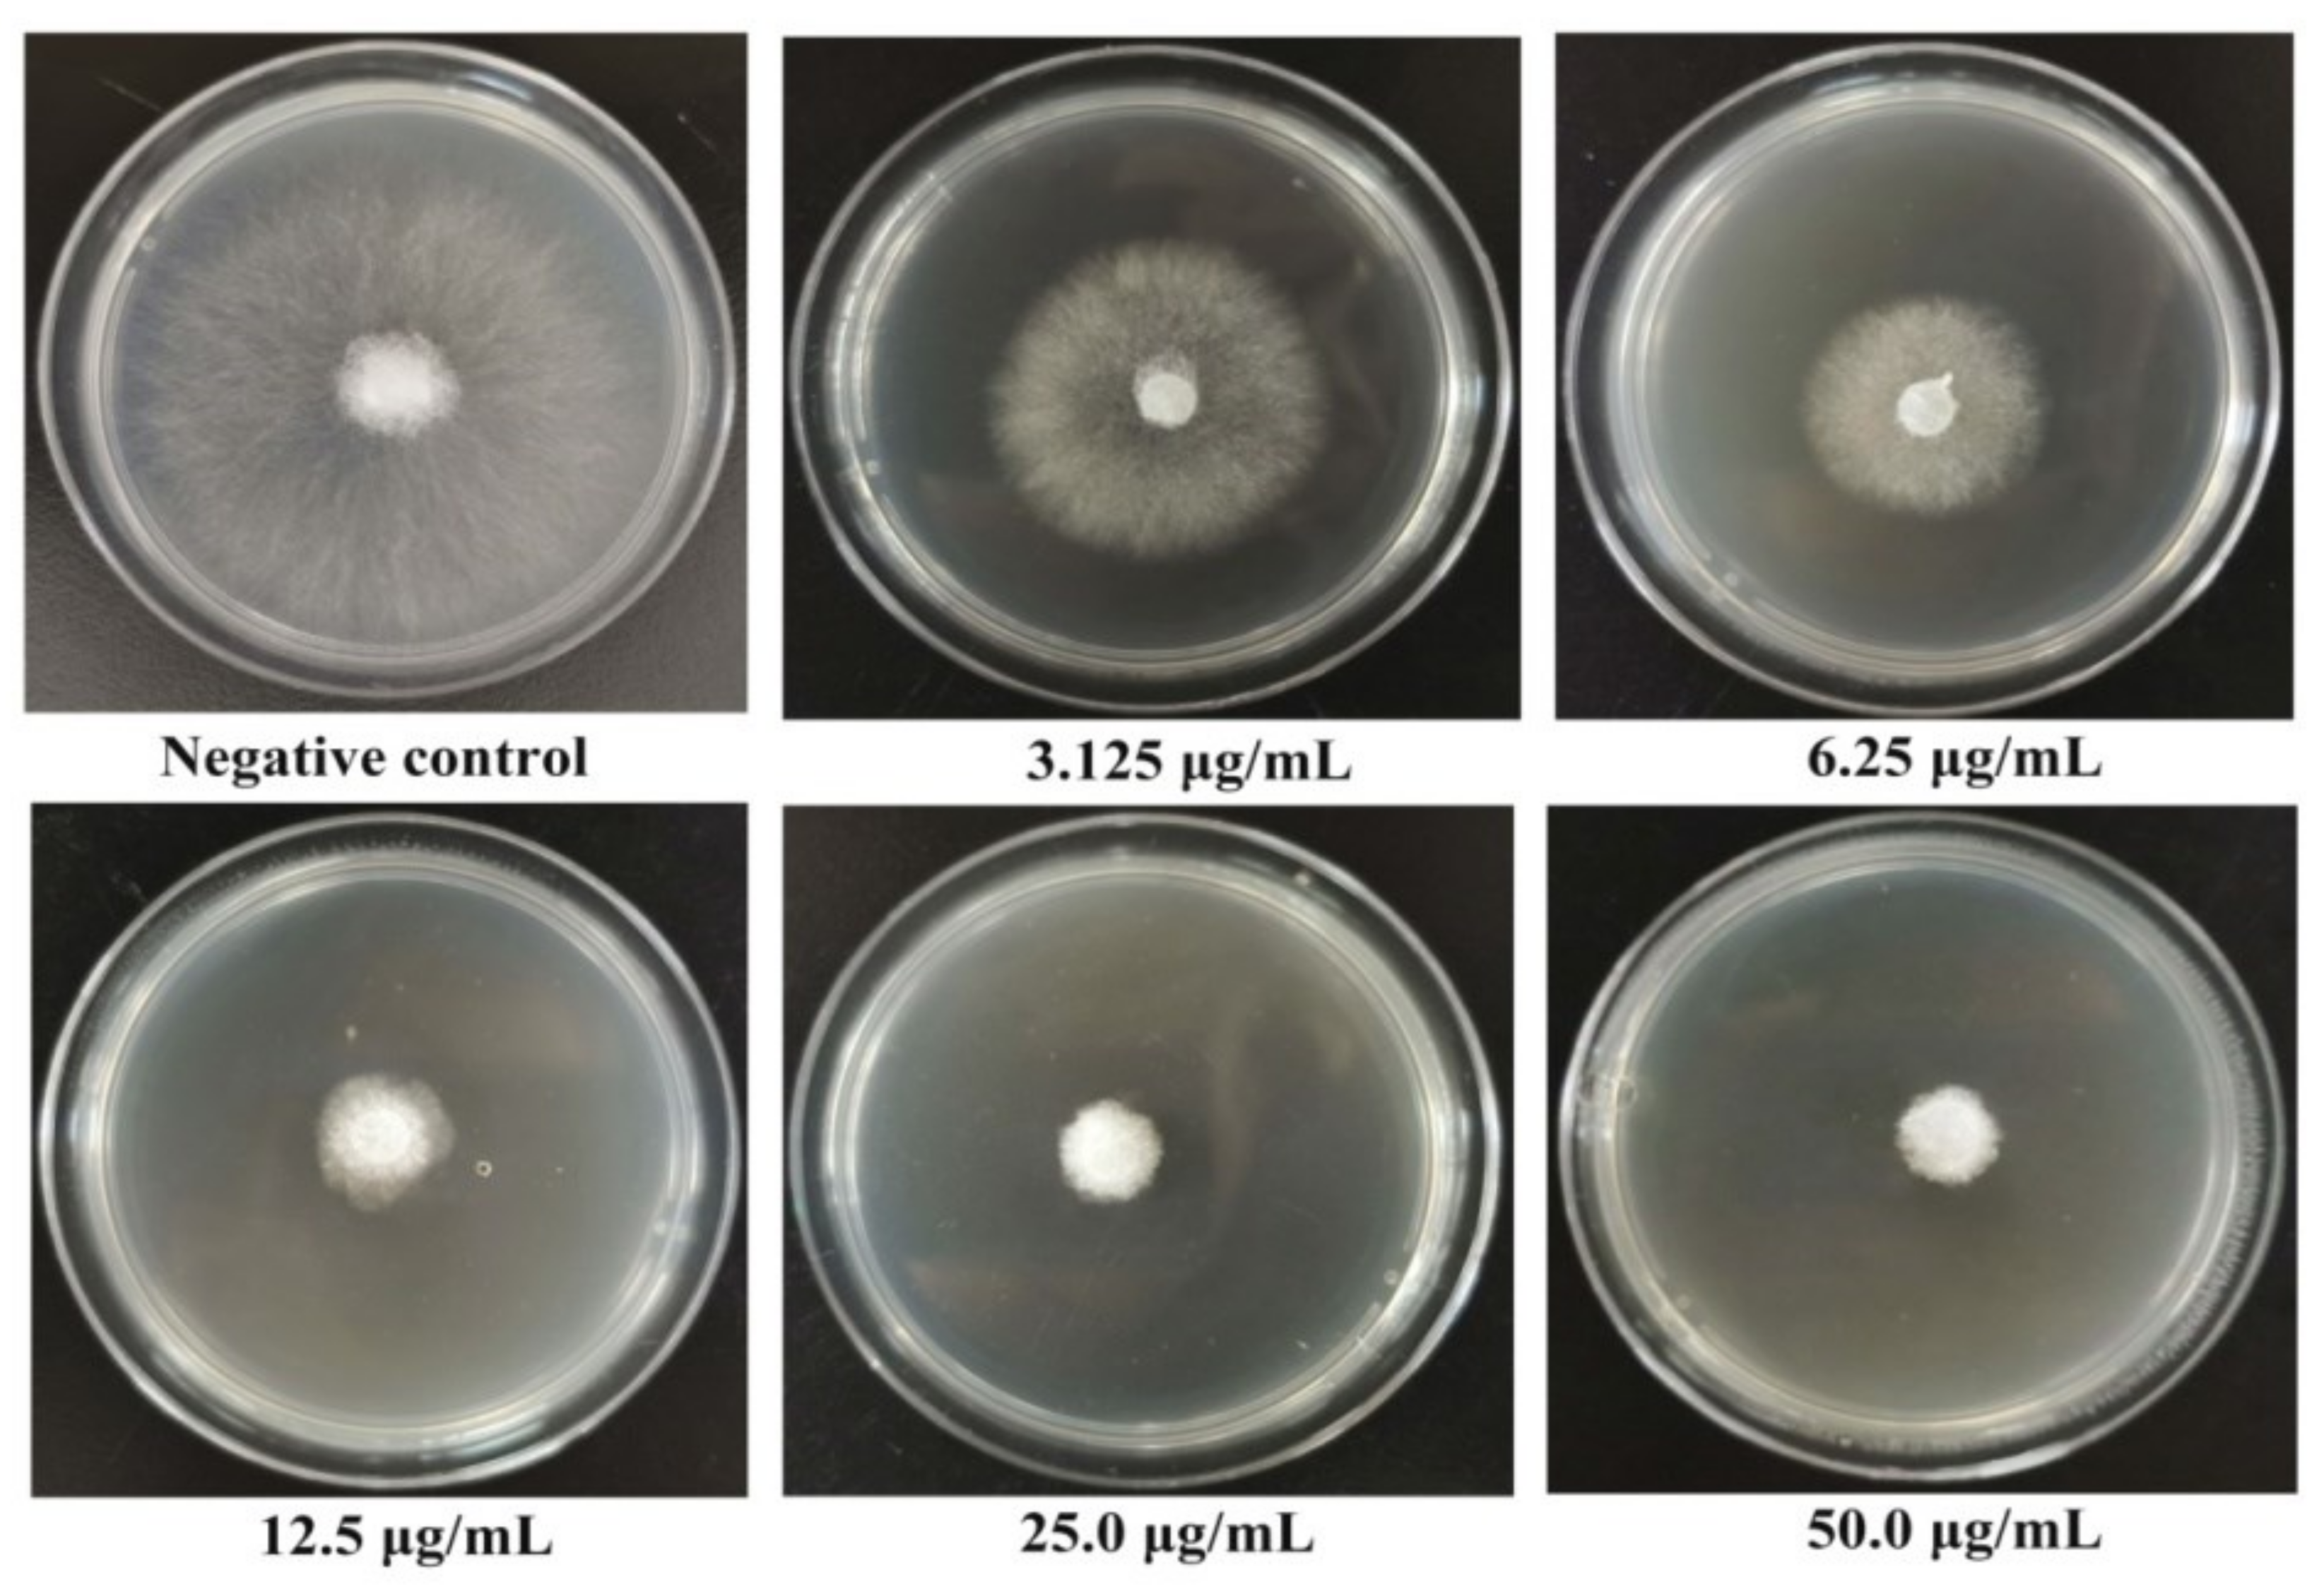
Ijms 23 01596 g003 550

Design, Synthesis and Antifungal/Nematicidal Activity of Novel 1,2,4-Oxadiazole Derivatives Containing Amide Fragments
Abstract
:1. Introduction
2. Result and Discussion
2.1. Chemistry
2.2. In Vitro Antifungal Bioassay
2.3. Cytotoxicity Assays
2.4. In Vivo Anti-S. sclerotiorum Bioassay
2.5. Nematocidal Bioassay
2.6. Scanning Electron Microscopy (SEM) of Compound F15 on the Hyphae Morphology
2.7. Enzymatic Inhibition Activity of SDH
2.8. Molecular Docking Study
3. Materials and Methods
3.1. Chemistry
3.1.1. Instruments and Chemicals
3.1.2. General Procedure for the Synthesis of Intermediate a1–a6
3.1.3. General Procedure for the Synthesis of Intermediate b1–b6
3.1.4. General Procedure for the Synthesis of Intermediate d1–d6
3.1.5. General Procedure for the Synthesis of Target Compounds F1–F24
3.2. Antifungal Activity Bioassay In Vitro
3.3. Cytotoxicity Assays In Vitro
3.4. Nematicidal Activity Bioassay In Vitro
3.5. Antifungal Activity Bioassay In Vivo
3.6. SDH Enzyme Activities Bioassay
3.7. SEM Observations
3.8. Molecular Docking
4. Conclusions
Supplementary Materials
Author Contributions
Funding
Institutional Review Board Statement
Informed Consent Statement
Data Availability Statement
Conflicts of Interest
References
- Lucas, G.B.; Campbell, C.L.; Lucas, L.T. Causes of plant diseases. In Introduction to Plant Diseases; Springer: Berlin/Heidelberg, Germany, 1992; pp. 9–14. [Google Scholar] [CrossRef]
- Chitwood, D.J. Research on plant-parasitic nematode biology conducted by the United States Department of Agriculture–Agricultural Research Service. Pest. Manag. Sci. 2003, 59, 748–753. [Google Scholar] [CrossRef] [PubMed]
- Wu, H.B.; Wu, H.B.; Kuang, M.S.; Lan, H.P.; Wen, Y.X.; Liu, T.T. Novel bithiophene dimers from Echinops latifolius as potential antifungal and nematicidal agents. J. Agric. Food Chem. 2020, 68, 11939–11945. [Google Scholar] [CrossRef] [PubMed]
- Akhtar, M. Nematicidal potential of the neem tree Azadirachta indica (A. Juss). Int. J. Pest Manag. 2000, 5, 57–66. [Google Scholar] [CrossRef]
- Son, S.H.; Khan, Z.; Kim, S.G.; Kim, Y.H. Plant growth-promoting rhizobacteria, Paenibacillus polymyxa and Paenibacillus lentimorbus suppress disease complex caused by root-knot nematode and fusarium wilt fungus. J. Appl. Microbiol. 2009, 107, 524–532. [Google Scholar] [CrossRef] [PubMed]
- Dang, Q.L.; Kim, W.K.; Nguyen, C.M.; Choi, Y.H.; Choi, G.J.; Jang, K.S.; Park, M.S.; Lim, C.H.; Luu, N.H.; Kim, J.C. Nematicidal and antifungal activities of annonaceous acetogenins from Annona squamosa against various plant pathogens. J. Agric. Food Chem. 2011, 59, 11160–11167. [Google Scholar] [CrossRef] [PubMed]
- Xie, J.L.; Yang, F.; Wang, Y.P.; Peng, Y.L.; Ji, H.L. Studies on the efficiency of different inoculation methods of rice white-tip nematode, Aphelenchoides besseyi. Nematology 2019, 21, 673–678. [Google Scholar] [CrossRef] [Green Version]
- Abad, P.; Gouzy, J.; Aury, J.M.; Castagnone-Sereno, P.; Danchin, E.G.J.; Deleury, E.; Perfus-Barbeoch, L.; Anthouard, V.; Artiguenave, F.; Blok, V.C.; et al. Genome sequence of the metazoan plant-parasitic nematode Meloidogyne incognita. Nat. Biotechnol. 2008, 26, 909–915. [Google Scholar] [CrossRef] [Green Version]
- Rastija, V.; Vrandečić, K.; Ćosić, J.; Majić, I.; Šarić, G.K.; Agić, D.; Karnaš, M.; Lončarić, M.; Molnar, M. Biological activities related to plant protection and environmental effects of coumarin derivatives: QSAR and molecular docking studies. Int. J. Mol. Sci. 2021, 22, 7283. [Google Scholar] [CrossRef]
- Burns, A.R.; Bagg, R.; Yeo, M.; Luciani, G.M.; Schertzberg, M.; Fraser, A.G.; Roy, P.J. The novel nematicide wact-86 interacts with aldicarb to kill nematodes. PLoS Negl. Trop. Dis. 2017, 11, e0005502. [Google Scholar] [CrossRef] [PubMed]
- Ntalli, N.G.; Caboni, P. Botanical nematicides: A review. J. Agric. Food Chem. 2012, 60, 9929–9940. [Google Scholar] [CrossRef]
- Jones, J.K.; Kleczewski, N.M.; Desaeger, J.; Meyer, S.L.F.; Johnson, G.C. Evaluation of nematicides for southern root-knot nematode management in lima bean. Crop Prot. 2017, 96, 151–157. [Google Scholar] [CrossRef] [Green Version]
- Yan, Z.; Liu, A.; Huang, M.; Liu, M.; Pei, H.; Huang, L.; Yi, H.B.; Liu, W.D.; Hu, A.X. Design, synthesis, DFT study and antifungal activity of the derivatives of pyrazolecarboxamide containing thiazole or oxazole ring. Eur. J. Med. Chem. 2018, 149, 170–181. [Google Scholar] [CrossRef] [PubMed]
- Wang, M.L.; Du, Y.; Ling, C.; Yang, Z.K.; Jiang, B.B.; Duan, H.X.; An, X.; Li, X.H.; Yang, X.L. Design, synthesis and antifungal/anti-oomycete activity of pyrazolyl oxime ethers as novel potential succinate dehydrogenase inhibitors. Pest Manag. Sci. 2021, 77, 3910–3920. [Google Scholar] [CrossRef] [PubMed]
- Cecchini, G. Function and structure of complex II of the respiratory chain. Annu. Rev. Biochem. 2003, 72, 77–109. [Google Scholar] [CrossRef] [PubMed] [Green Version]
- Sun, F.; Huo, X.; Zhai, Y.; Wang, A.; Xu, J.; Su, D.; Bartlam, M.; Rao, Z. Crystal structure of mitochondrial respiratory membrane protein complex II. Cell 2005, 121, 1043–1057. [Google Scholar] [CrossRef] [Green Version]
- Miles, D.T.; Miles, L.A.; Fairchild, K.L.; Wharton, P.S. Screening and characterization of resistance to succinate dehydrogenase inhibitors in Alternaria solani. Plant Pathol. 2014, 63, 155–164. [Google Scholar] [CrossRef]
- Lahm, G.P.; Desaeger, J.; Smith, B.K.; Pahutski, T.F.; Rivera, M.A.; Meloro, T.; Kucharczyk, R.; Lett, R.M.; Daly, A.; Smith, B.T.; et al. The discovery of fluazaindolizine: A new product for the control of plant parasitic nematodes. Bioorg. Med. Chem. Lett. 2017, 27, 1572–1575. [Google Scholar] [CrossRef]
- Yamashita, M.; Fraaije, B. Non-target site SDHI resistance is present as standing genetic variation infield populations of Zymoseptoria tritici. Pest Manag. Sci. 2017, 74, 672–681. [Google Scholar] [CrossRef] [Green Version]
- Wang, X.B.; Wang, A.; Qiu, L.L.; Chen, M.; Li, G.H.; Yang, C.L. Expedient discovery for novel antifungal leads targeting succinate dehydrogenase: Pyrazole-4-formylhydrazide derivatives bearing a diphenyl ether fragment. J. Agric. Food Chem. 2020, 68, 14426–14437. [Google Scholar] [CrossRef]
- Miyamoto, T.; Hayashi, K.; Okada, R.; Wari, D.; Ogawara, T. Resistance to succinate dehydrogenase inhibitors in field isolates of Podosphaera xanthii on cucumber: Monitoring, cross-resistance patterns and molecular characterization. Pestic. Biochem. Physiol. 2020, 169, 104646. [Google Scholar] [CrossRef]
- Ji, X.X.; Li, J.J.; Dong, B.; Zhang, H.; Zhang, S.A.; Qiao, K. Evaluation of fluopyram for southern root-knot nematode management in tomato production in China. Crop Prot. 2019, 122, 84–89. [Google Scholar] [CrossRef]
- Hang, T.H.; Chen, H.; Chen, J.; Zhang, A.D. Syntheses, crystal structures, and biological activities of two 5-pyrimidinyl-1,2,4-oxadiazoles. Chin. J. Struc. Chem. 2014, 10, 1455–1459. [Google Scholar] [CrossRef]
- Ryu, E.K.; Chung, K.H.; Lee, W.H.; Kim, J.N.; Hong, K.S. Herbicidal Quinolinyl Oxadiazoles. WO Patent WO9404530A1, 3 March 1994. [Google Scholar]
- Zhu, L.Z.; Zeng, H.N.; Liu, D.; Fu, Y.; Wu, Q.; Song, B.A.; Gan, X.H. Design, synthesis, and biological activity of novel 1,2,4-oxadiazole derivatives. BMC Chem. 2020, 14, 68. [Google Scholar] [CrossRef] [PubMed]
- Karad, S.C.; Purohit, V.B.; Thummar, R.P.; Vaghasiya, B.K.; Kamani, R.D.; Thakor, P.; Thakkar, V.R.; Thakkar, S.S. Synthesis and biological screening of novel 2-morpholinoquinoline nucleus clubbed with 1,2,4-oxadiazole motifs. Eur. J. Med. Chem. 2017, 126, 894–909. [Google Scholar] [CrossRef] [PubMed]
- Yang, S.; Ren, C.L.; Ma, T.Y.; Zou, W.Q.; Dai, L.; Tian, X.Y.; Liu, X.H.; Tan, C.X. 1,2,4-Oxadiazole-based bio-isosteres of benzamides: Synthesis, biological activity and toxicity to zebrafish embryo. Int. J. Mol. Sci. 2021, 22, 2367. [Google Scholar] [CrossRef]
- Iwata, J.; Nakamura, Y.; Hayashi, T.; Watanabe, S.; Sano, H. Oxadiazole Compound and Fungicide for Agricultural and Horticultural Use. WO Patent WO2019022061A1, 31 January 2019. [Google Scholar]
- Sangshetti, J.N.; Nagawade, R.R.; Shinde, D.B. Synthesis of novel 3-(1-(1-substitutedpiperidin-4-yl)-1H-1,2,3-triazol-4-yl)-1,2,4-oxadiazol-5 (4H)-one as antifungal agents. Bioorg. Med. Chem. Lett. 2009, 19, 3564–3567. [Google Scholar] [CrossRef]
- Maciel, L.G.; Oliveira, A.A.; Romão, T.P.; Leal, L.L.L.; Guido, R.V.C.; Silva Filha, M.H.N.L.; Dos Anjos, J.V.; Soares, T.A. Discovery of 1,2,4-oxadiazole derivatives as a novel class of noncompetitive inhibitors of 3-hydroxykynurenine transaminase (HKT) from Aedes aegypti. Bioorg. Med. Chem. 2019, 28, 155252. [Google Scholar] [CrossRef]
- Fernandes, F.S.; Santos, H.; Lima, S.R.; Conti, C.; Rodrigues, M.T.; Zeoly, L.A.; Ferreira, L.L.G.; Krogh, R.; Andricopulo, A.D.; Coelho, F. Discovery of highly potent and selective antiparasitic new oxadiazole and hydroxy-oxindole small molecule hybrids. Eur. J. Med. Chem. 2020, 201, 112418. [Google Scholar] [CrossRef]
- Hemming, K. Recent developments in the synthesis, chemistry and applications of the fully unsaturated 1,2,4-oxadiazoles. J. Chem. Res. 2001, 209–216. [Google Scholar] [CrossRef]
- Jalhan, S. Various Biological Activities of Coumarin and Oxadiazole Derivatives. Asian J. Pharm. Clin. Res. 2017, 10, 38–43. [Google Scholar] [CrossRef] [Green Version]
- Biernacki, K.; Dásko, M.; Ciupak, O.; Kubiński, K.; Rachon, J.; Demkowicz, S. Novel 1,2,4-oxadiazole derivatives in drug discovery. Pharmaceuticals 2020, 13, 111. [Google Scholar] [CrossRef]
- Dhameliya, T.M.; Chudasma, S.C.; Patel, T.M.; Dave, B.P. A review on synthetic account of 1,2,4-oxadiazoles as anti-infective agents. Mol. Divers. 2022. online ahead of print. [Google Scholar] [CrossRef] [PubMed]
- Slomczynska, U.; South, M.S.; Bunkers, G.J.; Edgecomb, D.; Wyse-Pester, D.; Selness, S.; Ding, Y.W.; Christiansen, J.; Ediger, K.; Miller, W.; et al. Tioxazafen: A new broad-spectrum seed treatment nematicide. J. Am. Chem. Soc. 2015, 10, 129–147. [Google Scholar] [CrossRef]
- Zhang, M.M.; Sun, J.X.; Xu, Z.L.; Wang, M.H. Development of a novel type of 3,5-disubstituted-1,2,4-oxadiazole insecticide. Mod. Agrochem. 2018, 18, 18–20. [Google Scholar] [CrossRef]
- Shetnev, S.; Baykov, S.; Kalinin, S.; Belova, A.; Sharoyko, V.; Rozhkov, A.; Zelenkov, L.; Tarasenko, M.; Sadykov, E.; Korsakov, M.; et al. 1,2,4-Oxadiazole/2-imidazoline hybrids: Multi-target-directed compounds for the treatment of infectious diseases and cancer. Int. J. Mol. Sci. 2019, 20, 1699. [Google Scholar] [CrossRef] [PubMed] [Green Version]
- Voronova, A.A.; Baikov, S.V.; Krasovskaya, G.G.; Kolobov, A.V.; Kofanov, E.R. Some regularities of the synthesis of ethyl 3-aryl-1,2,4-oxadiazole-5-carboxylates. Russ. J. Org. Chem. 2014, 50, 1683–1686. [Google Scholar] [CrossRef]
- Liu, M.M.; Liang, Y.R.; Zhu, Z.Z.; Wang, J.; Cheng, X.X.; Cheng, J.Y.; Xu, B.P.; Li, R.; Liu, X.H.; Wang, Y. Discovery of novel aryl carboxamide derivatives as hypoxia-inducible factor 1α signaling inhibitors with potent activities of anticancer metastasis. J. Med. Chem. 2019, 62, 9299–9314. [Google Scholar] [CrossRef]
- Zhang, T.T.; Liu, H.; Lu, T.; Zhang, G.L.; Xiao, T.T.; Cheng, W.; Wang, J.W.; Jiang, W.J.; Tang, X.R. Novel 4,5-dihydro-1H-pyrazole derivatives as potential succinate dehydrogenase inhibitors: Design, synthesis, crystal structure, biological activity and molecular modeling. J. Mol. Struct. 2022, 1249, 131537. [Google Scholar] [CrossRef]
- Case, D.A.; Betz, R.M.; Cerutti, D.S.; Cheatham, T.E.; Darden, T.A.; Duke, R.E.; Kollman, P.A. Amber 2016 Reference Manual; University of California: San Francisco, CA, USA, 2016; pp. 1–923. [Google Scholar] [CrossRef]
- Sun, N.B.; Shi, Y.X.; Liu, X.H.; Ma, Y.; Tan, C.X.; Weng, J.Q.; Jin, J.Z.; Li, B.J. Design, synthesis, antifungal activities and 3D-QSAR of new N,N’-diacylhydrazines containing 2,4-dichlorophenoxy moiety. Int. J. Mol. Sci. 2013, 14, 21741–21756. [Google Scholar] [CrossRef] [PubMed] [Green Version]
- Li, S.K.; Li, D.D.; Xiao, T.F.; Zhang, S.S.; Song, Z.H.; Ma, H.Y. Design, synthesis, fungicidal activity and unexpected docking model of the first chiral boscalid analogues containing oxazolines. J. Agric. Food Chem. 2016, 64, 8927–8934. [Google Scholar] [CrossRef]
- Zhang, Y.Q.; Wen, Z.H.; Wan, K.; Yuan, D.B.; Zeng, X.P.; Liang, G.Y.; Zhu, J.G.; Xu, B.X.; Luo, H. A novel synthesized 3′,5′-diprenylated chalcone mediates the proliferation of human leukemia cells by regulating apoptosis and autophagy pathways. Biomed. Pharmacother. 2018, 106, 794–804. [Google Scholar] [CrossRef] [PubMed]
- Xu, S.C.; Zeng, X.J.; Dai, S.L.; Wang, J.; Chen, Y.X.; Song, J.; Shi, Y.F.; Cheng, X.; Liao, S.L.; Zhao, Z.D. Turpentine derived secondary amines for sustainable crop protection: Synthesis, activity evaluation and QSAR study. J. Agric. Food Chem. 2020, 68, 11829–11838. [Google Scholar] [CrossRef] [PubMed]
- Tao, Q.Q.; Liu, L.W.; Wang, P.Y.; Long, Q.S.; Zhao, Y.L.; Jin, L.H.; Xu, W.M.; Chen, Y.; Li, Z.; Yang, S. Synthesis and in vitro and in vivo biological activity evaluation and quantitative proteome profiling of oxadiazoles bearing flexible heterocyclic patterns. J. Agric. Food Chem. 2019, 67, 7626–7639. [Google Scholar] [CrossRef] [PubMed]
- Hua, X.W.; Liu, N.N.; Zhou, S.; Zhang, L.L.; Yin, H.; Wang, G.Q.; Fan, Z.J.; Ma, Y. Design, synthesis, and biological activity of novel aromatic amide derivatives containing sulfide and sulfone substructures. Engineering 2020, 6, 553–559. [Google Scholar] [CrossRef]
- Wei, C.Q.; Huang, J.J.; Luo, Y.Q.; Wang, S.B.; Wu, S.K.; Xing, Z.F.; Chen, J.X. Novel amide derivatives containing an imidazo [1,2-α] pyridine moiety: Design, synthesis as potential nematicidal and antibacterial agents. Pestic. Biochem. Physiol. 2021, 175, 104857. [Google Scholar] [CrossRef]
- Yang, G.Z.; Zhu, J.K.; Yin, X.D.; Yan, Y.F.; Wang, Y.L.; Shang, X.F.; Liu, Y.Q.; Zhao, Z.M.; Peng, J.W.; Liu, H. Design, synthesis, and antifungal evaluation of novel quinoline derivatives inspired from natural quinine alkaloids. J. Agric. Food Chem. 2019, 67, 11340–11353. [Google Scholar] [CrossRef]
- Peng, J.W.; Yin, X.D.; Li, H.; Ma, K.Y.; Zhang, Z.J.; Zhang, R.; Wang, Y.L.; Hu, G.F.; Liu, Y.Q. Design, synthesis, and structure−activity relationship of quinazolinone derivatives as potential fungicides. J. Agric. Food Chem. 2021, 69, 4604–4614. [Google Scholar] [CrossRef]
- Li, H.; Gao, M.Q.; Chen, Y.; Wang, Y.X.; Zhu, X.L.; Yang, G.F. Discovery of pyrazine-carboxamide-diphenyl-ethers as novel succinate dehydrogenase inhibitors via fragment recombination. J. Agric. Food Chem. 2020, 68, 14001–14008. [Google Scholar] [CrossRef]
- Wu, Z.B.; Park, H.Y.; Xie, D.W.; Yang, J.X.; Hou, S.T.; Shahzad, N.; Kim, C.K.; Yang, S. Synthesis, biological evaluation, and 3D-QSAR studies of N-(substituted pyridine-4-yl)-1-(substituted phenyl)-5-trifluoromethyl-1H-pyrazole-4-carboxamide derivatives as potential succinate dehydrogenase inhibitors. J. Agric. Food Chem. 2021, 69, 1214–1223. [Google Scholar] [CrossRef]
- Zhang, J.; Yang, L.T.; Yuan, E.L.; Ding, H.X.; Ye, H.C.; Zhang, Z.K.; Yan, C.; Liu, Y.Q.; Feng, G. Antifungal activity of compounds extracted from cortex pseudolaricis against Colletotrichum gloeosporioides. J. Agric. Food Chem. 2014, 62, 4905–4910. [Google Scholar] [CrossRef]
- Zhang, A.G.; Zhou, J.Y.; Tao, K.; Hou, T.P.; Jin, H. Design, synthesis and antifungal evaluation of novel pyrazole carboxamides with diarylamines scaffold as potent succinate dehydrogenase inhibitors. Bioorg. Med. Chem. Lett. 2018, 28, 3042–3045. [Google Scholar] [CrossRef]
- Xiong, L.; Li, H.; Jiang, L.N.; Ge, J.M.; Yang, W.C.; Zhu, X.L.; Yang, G.F. Structure-based discovery of potential fungicides as succinate ubiquinone oxidoreductase inhibitors. J. Agric. Food Chem. 2017, 65, 1021–1029. [Google Scholar] [CrossRef] [PubMed]
- Sitkoff, D.; Sharp, K.A.; Honig, B. Accurate calculation of hydration free energies using macroscopic solvent models. J. Phys. Chem. 1994, 98, 1978–1988. [Google Scholar] [CrossRef]
- Wang, J.M.; Wang, W.; Kollman, P.A.; Case, D.A. Automatic atom type and bond type perception in molecular mechanical calculations. J. Mol. Graph. Model. 2006, 25, 247–260. [Google Scholar] [CrossRef] [PubMed]

| Compound | R | R′ | n | Inhibition Rate (%) a | |
|---|---|---|---|---|---|
| B. cinerea | S. sclerotiorum | ||||
| F1 | C6H5 | 2-Py | 2 | 24.2 ± 0.2 | 73.2 ± 0.1 |
| F2 | C6H5 | 3-Cl-5-CF3-2-Py | 2 | 23.6 ± 0.6 | 48.6 ± 1.6 |
| F3 | C6H5 | 2,4-di-F-C6H3 | 1 | 56.8 ± 0.1 | 84.8 ± 0.6 |
| F4 | C6H5 | 2,4-di-Cl-C6H3 | 0 | 20.9 ± 0.1 | 31.2 ± 0.7 |
| F5 | 4-CH3-C6H4 | 2-Py | 2 | 24.9 ± 1.6 | 56.3 ± 1.2 |
| F6 | 4-CH3-C6H4 | 3-Cl-5-CF3-2-Py | 2 | 22.9 ± 1.1 | 56.0 ± 1.4 |
| F7 | 4-CH3-C6H4 | 2,4-di-F-C6H3 | 1 | 46.4 ± 0.8 | 56.4 ± 0.1 |
| F8 | 4-CH3-C6H4 | 2,4-di-Cl-C6H3 | 0 | 22.7 ± 1.3 | 21.1 ± 1.7 |
| F9 | 4-Cl-C6H4 | 2-Py | 2 | 26.7 ± 0.5 | 61.1 ± 0.7 |
| F10 | 4-Cl-C6H4 | 3-Cl-5-CF3-2-Py | 2 | 24.2 ± 1.7 | 48.6 ± 1.2 |
| F11 | 4-Cl-C6H4 | 2,4-di-F-C6H3 | 1 | 44.2 ± 1.2 | 44.9 ± 0.9 |
| F12 | 4-Cl-C6H4 | 2,4-di-Cl-C6H3 | 0 | 29.1 ± 1.4 | 24.8 ± 1.4 |
| F13 | thienyl | 2-Py | 2 | 27.3 ± 0.4 | 41.1 ± 0.1 |
| F14 | thienyl | 3-Cl-5-CF3-2-Py | 2 | 36.4 ± 0.2 | 65.2 ± 0.2 |
| F15 | thienyl | 2,4-di-F-C6H3 | 1 | 58.2 ± 0.2 | 89.3 ± 0.4 |
| F16 | thienyl | 2,4-di-Cl-C6H3 | 0 | 25.5 ± 0.6 | 39.6 ± 0.1 |
| F17 | 6-Br-3-Py | 2-Py | 2 | 27.6 ± 1.4 | 10.1 ± 1.2 |
| F18 | 6-Br-3-Py | 3-Cl-5-CF3-2-Py | 2 | 55.9 ± 1.3 | 34.9 ± 1.1 |
| F19 | 6-Br-3-Py | 2,4-di-F-C6H3 | 1 | 42.2 ± 0.2 | 35.8 ± 0.8 |
| F20 | 6-Br-3-Py | 2,4-di-Cl-C6H3 | 0 | 55.8 ± 0.1 | 13.8 ± 0.5 |
| F21 | 3-Cl-5-CF3-2-Py | 2-Py | 2 | 38.8 ± 0.7 | 35.1 ± 0.1 |
| F22 | 3-Cl-5-CF3-2-Py | 3-Cl-5-CF3-2-Py | 2 | 45.2 ± 0.9 | 37.6 ± 1.9 |
| F23 | 3-Cl-5-CF3-2-Py | 2,4-di-F-C6H3 | 1 | 41.5 ± 0.5 | 34.6 ± 0.1 |
| F24 | 3-Cl-5-CF3-2-Py | 2,4-di-Cl-C6H3 | 0 | 38.5 ± 0.5 | 1.8 ± 0.8 |
| Fluopyram | 87.3 ± 0.6 | 93.7 ± 1.7 | |||
| Thifluzamide | 80.3 ± 0.2 | 86.7 ± 0.3 | |||
| Compound | EC50 (μg/mL) a | 95% Confidence Interval | Regression Equation | R | Cytotoxicity (%) a | ||
|---|---|---|---|---|---|---|---|
| 200 μg/mL | 100 μg/mL | 50 μg/mL | |||||
| F1 | 20.8 ± 0.8 | 17.2–25.9 | Y = −2.4 + 1.9x | 0.95 | 15.4 ± 4.4 | 10.9 ± 5.9 | 4.7 ± 4.9 |
| F3 | 5.4 ± 0.3 | 4.0–6.8 | Y = −1.6 + 2.2x | 0.93 | 50.8 ± 3.9 | 17.0 ± 1.4 | 7.5 ± 3.8 |
| F9 | 18.7 ± 0.4 | 12.6–31.7 | Y = −1.4 + 1.1 x | 0.94 | 31.5 ± 8.7 | 7.1 ± 6.5 | −2.5 ± 0.2 |
| F14 | 15.3 ± 1.3 | 10.5–23.6 | Y = −1.3 + 1.1x | 0.99 | 39.1 ± 8.4 | 21.4 ± 5.0 | 18.8 ± 2.5 |
| F15 | 2.9 ± 1.3 | 1.6–4.1 | Y = −0.8 + 1.8x | 0.96 | 37.4 ± 0.2 | 11.3 ± 4.8 | 1.4 ± 2.2 |
| Fluopyram | 1.2 ± 1.6 | 0.7–2.0 | Y = −0.1 + 0.9x | 0.97 | 55.1 ± 0.4 | 40.1 ± 1.2 | 3.8 ± 2.5 |
| Thifluzamide | 4.3 ± 1.7 | 2.5–7.5 | Y = −0.5 + 0.9x | 0.94 | 33.9 ± 1.5 | 33.7 ± 0.4 | 33.3 ± 1.8 |
| Compound | Concentration (μg/mL) | Curative Effect | Protective Effect | ||
|---|---|---|---|---|---|
| Lesion Length (mm ± SD) | Control Efficacy (%) | Lesion Length (mm ± SD) | Control Efficacy (%) | ||
| F15 | 100 | 8.3 ± 0.7 | 62.3 | 6.9 ± 0.2 | 71.0 |
| 50 | 11.0 ± 0.4 | 50.0 | 8.1 ± 0.5 | 66.0 | |
| 25 | 15.9 ± 0.3 | 27.7 | 10.4 ± 0.7 | 56.3 | |
| Fluopyram | 100 | 5.7 ± 0.6 | 74.1 | 5.8± 0.1 | 75.6 |
| 50 | 6.3 ± 0.2 | 71.4 | 7.3 ± 0.2 | 69.3 | |
| 25 | 7.7 ± 0.6 | 65.0 | 7.9 ± 0.1 | 66.8 | |
| Control | – | 22.0 ± 0.8 | – | 23.8 ± 0.3 | – |
| Compound | Corrected Mortality Rate ± SD (%) a | |||||||
|---|---|---|---|---|---|---|---|---|
| M. incognita | C. elegans | B. xylophilus | A. besseyi | |||||
| 200 µg/mL | 50 µg/mL | 200 µg/mL | 50 µg/mL | 200 µg/mL | 50 µg/mL | 200 µg/mL | 50 µg/mL | |
| F1 | 43.5 ± 2.3 | 6.9 ± 2.1 | 88.7 ± 1.3 | 51.3 ± 2.2 | 6.1 ± 1.1 | 0.0 | 6.9 ± 1.2 | 0.0 |
| F2 | 42.6 ± 3.6 | 7.4 ± 3.2 | 46.7 ± 2.6 | 10.3 ± 1.4 | 5.5 ± 1.6 | 0.0 | 15.1 ± 1.6 | 0.0 |
| F3 | 54.9 ± 3.3 | 13.9 ± 2.1 | 100.0 | 100.0 | 26.1 ± 1.2 | 0.0 | 20.1 ± 1.3 | 0.0 |
| F4 | 23.2 ± 1.4 | 5.9 ± 1.3 | 98.4 ± 2.3 | 71.4 ± 2.2 | 25.3 ± 1.7 | 0.0 | 11.7 ± 1.4 | 0.0 |
| F5 | 35.0 ± 2.2 | 3.5 ± 1.3 | 94.6 ± 1.7 | 67.9 ± 2.3 | 8.1 ± 2.2 | 0.0 | 22.5 ± 3.2 | 0.0 |
| F6 | 44.6 ± 3.8 | 7.9 ± 2.2 | 100.0 | 100.0 | 11.6 ± 2.1 | 0.0 | 29.4 ± 2.3 | 0.0 |
| F7 | 24.9 ± 3.2 | 5.3 ± 1.1 | 91.9 ± 2.5 | 68.2 ± 2.3 | 28.1 ± 2.4 | 0.0 | 12.2 ± 2.1 | 0.0 |
| F8 | 23.9 ± 3.3 | 4.9 ± 2.1 | 77.6 ± 1.2 | 47.6 ± 1.7 | 18.1 ± 1.2 | 0.0 | 6.1 ± 1.2 | 0.0 |
| F9 | 56.3 ± 2.4 | 9.8 ± 2.5 | 87.6 ± 1.1 | 62.1 ± 2.2 | 14.5 ± 2.5 | 0.0 | 12.8 ± 2.3 | 0.0 |
| F10 | 15.8 ± 3.5 | 0.0 | 100.0 | 69.3 ± 1.8 | 12.1 ± 1.7 | 0.0 | 23.6 ± 2.2 | 0.0 |
| F11 | 93.2 ± 2.1 | 24.8 ± 2.2 | 73.6 ± 1.7 | 10.6 ± 1.3 | 23.2 ± 2.1 | 0.0 | 19.8 ± 2.1 | 0.0 |
| F12 | 54.8 ± 2.5 | 13.8 ± 2.3 | 47.6 ± 1.2 | 8.6 ± 1.6 | 20.8 ± 2.5 | 0.0 | 18.8 ± 1.1 | 0.0 |
| F13 | 11.6 ± 1.1 | 0.0 | 100.0 | 70.4 ± 2.6 | 9.1 ± 1.5 | 0.0 | 21.7 ± 2.4 | 0.0 |
| F14 | 12.3 ± 2.3 | 0.0 | 100.0 | 70.0 ± 0.6 | 6.9 ± 1.8 | 0.0 | 27.0 ± 0.8 | 0.0 |
| F15 | 20.9 ± 2.2 | 3.9 ± 3.2 | 96.4 ± 1.5 | 67.4 ± 1.7 | 28.5 ± 1.1 | 0.0 | 13.6 ± 3.4 | 0.0 |
| F16 | 20.2 ± 3.1 | 4.1 ± 1.3 | 94.6 ± 2.1 | 65.5 ± 1.7 | 26.1 ± 1.4 | 0.0 | 14.7 ± 2.4 | 0.0 |
| F17 | 33.5 ± 1.4 | 0.0 | 89.7 ± 1.5 | 54.2 ±3.1 | 14.1 ± 1.9 | 0.0 | 20.2 ± 1.2 | 0.0 |
| F18 | 36.7 ± 2.1 | 0.0 | 90.0 ± 2.7 | 53.6 ± 2.4 | 15.1 ± 1.2 | 0.0 | 23.0 ± 2.3 | 0.0 |
| F19 | 30.7 ± 1.1 | 7.9 ± 1.2 | 93.5 ± 2.6 | 64.1 ± 1.2 | 30.7 ± 1.1 | 0.0 | 23.5 ± 2.6 | 0.0 |
| F20 | 41.2 ± 1.3 | 8.6 ± 2.2 | 100.0 | 81.4 ± 1.5 | 41.2 ± 1.3 | 0.0 | 26.4 ± 2.5 | 0.0 |
| F21 | 23.5 ± 2.4 | 0.0 | 76.8 ± 0.9 | 32.5 ± 2.0 | 7.1 ± 1.9 | 0.0 | 13.0 ± 0.5 | 0.0 |
| F22 | 18.3 ± 1.7 | 0.0 | 80.2 ± 1.5 | 45.7 ± 2.3 | 17.1 ± 2.2 | 0.0 | 26.5 ± 2.1 | 0.0 |
| F23 | 19.1 ± 2.2 | 0.0 | 27.6 ± 1.2 | 10.6 ± 1.2 | 20.3 ± 1.4 | 0.0 | 21.5 ± 2.2 | 0.0 |
| F24 | 18.5 ± 1.1 | 0.0 | 24.6 ± 1.4 | 9.6 ± 1.1 | 21.2 ± 1.5 | 0.0 | 23.4 ± 1.6 | 0.0 |
| Tioxazafen | 23.9 ± 3.3 | 12.6 ± 3.2 | 100.0 | 90.4 ± 0.7 | 13.5 ± 1.2 | 0.0 | 61.4 ± 1.7 | 8.8 ± 2.4 |
| Fosthiazate | 100.0 | 91.4 ± 2.5 | 100.0 | 100.0 | 72.4 ± 1.9 | 38.8 ± 1.3 | 38.4 ± 1.9 | 6.1 ± 3.1 |
| Fluopyram | 100.0 | 100.0 | 100.0 | 100.0 | 100.0 | 100.0 | 100.0 | 100.0 |
| Compound | IC50 (μg/mL) a | 95% Confidence Interval | Regression Equation | R |
|---|---|---|---|---|
| F15 | 12.5 ± 1.3 | 8.7–16.2 | y = −2.1x + 1.9 | 0.94 |
| Fluopyram | 7.9 ± 1.8 | 5.8–9.8 | y = −2.1x + 2.4 | 0.97 |
| Compound | ΔEvdw | ΔEele | ΔEMM | ΔGsol | ΔEbind | −TΔS | ΔGbind a |
|---|---|---|---|---|---|---|---|
| F15 | −137.1 | −8.0 | −145.1 | 44.8 | −100.3 | 13.6 | −86.8 |
| Fluopyram | −143.7 | −8.9 | −152.1 | 55.3 | −96.9 | 8.8 | −88.1 |
Publisher’s Note: MDPI stays neutral with regard to jurisdictional claims in published maps and institutional affiliations. |
© 2022 by the authors. Licensee MDPI, Basel, Switzerland. This article is an open access article distributed under the terms and conditions of the Creative Commons Attribution (CC BY) license (https://creativecommons.org/licenses/by/4.0/).
Share and Cite
Liu, D.; Luo, L.; Wang, Z.; Ma, X.; Gan, X. Design, Synthesis and Antifungal/Nematicidal Activity of Novel 1,2,4-Oxadiazole Derivatives Containing Amide Fragments. Int. J. Mol. Sci. 2022, 23, 1596. https://doi.org/10.3390/ijms23031596
Liu D, Luo L, Wang Z, Ma X, Gan X. Design, Synthesis and Antifungal/Nematicidal Activity of Novel 1,2,4-Oxadiazole Derivatives Containing Amide Fragments. International Journal of Molecular Sciences. 2022; 23(3):1596. https://doi.org/10.3390/ijms23031596
Chicago/Turabian StyleLiu, Dan, Ling Luo, Zhengxing Wang, Xiaoyun Ma, and Xiuhai Gan. 2022. "Design, Synthesis and Antifungal/Nematicidal Activity of Novel 1,2,4-Oxadiazole Derivatives Containing Amide Fragments" International Journal of Molecular Sciences 23, no. 3: 1596. https://doi.org/10.3390/ijms23031596
APA StyleLiu, D., Luo, L., Wang, Z., Ma, X., & Gan, X. (2022). Design, Synthesis and Antifungal/Nematicidal Activity of Novel 1,2,4-Oxadiazole Derivatives Containing Amide Fragments. International Journal of Molecular Sciences, 23(3), 1596. https://doi.org/10.3390/ijms23031596

